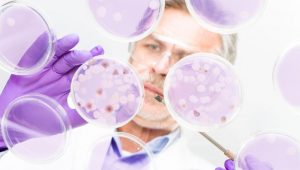
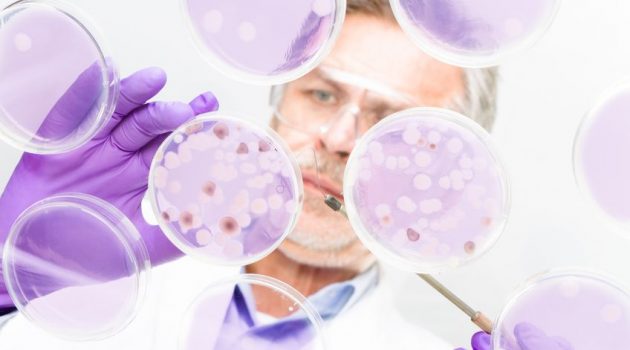

Aktuelles
Aktuelles
Bessere gesundheitliche Versorgung für Flüchtlinge!
Weltflüchtlingstag am 20.6.14 Minderjährige Flüchtlinge müssen das gleiche Recht auf bestmögliche medizinische Versorgung erhalten wie alle anderen Kinder in diesem Land. Das heißt: Zugang zu allen Gesundheitsleistungen entspre...
Aktuelles
Cholesterin: Zuviel im Blut ist riskant
Am 20.06.2014 findet der 12. “Tag des Cholesterins” statt. Dieser Aktionstag soll auf die Gefahr erhöhter Cholesterinwerte sowie auf die Risiken und Behandlung von Herz-Kreislauf-Erkrankungen hinweisen. Diese stellen in Deutsch...
Aktuelles
Stichproben-Analyse: Resistente Keime in Wurstwaren gefunden
Eine von den Grünen in Auftrag gegebene Stichproben-Analyse kam zu dem Ergebnis, dass Mett, Salami und Teewurst mit resistenten Bakterien belastet sind. In 16 Prozent den entnommenen Proben fand man derartige Keime. Insbesonder...
Aktuelles
Langlebigkeit: Lebenswerwartung deutlich gestiegen
Seit 1990 ist der Weltgesundheitsorganisation (WHO) zufolge die weltweite Lebenserwartung um sechs Jahre gestiegen. Am meisten aufholen konnten die armen Länder, wobei die reichen Staaten noch immer auf den vorderen Rängen führ...
Aktuelles
Bettwanzen und Milben: Unliebsame Krabbeltierchen im Bett
In den letzten Jahren sind sie vermehrt zurück in deutschen Haushalten: Die Bettwanzen. Entgegen einer naheliegenden Vermutung gedeihen sie aber nicht dort, wo es schmutzig und unordentlich ist, sondern sind vielmehr ein Proble...
Aktuelles
Bakterien überleben tagelang auf Flugzeugsitzen
US-Forscher warnen: Auf Armlehnen, Sitztaschen und Türknäufen im Flugzeug können Bakterien bis zu einer Woche überleben und auf diese Weise Krankheiten weiter verbreiten. Dies geht aus Studien hervor, die bei einem Kongress der...
Aktuelles
Vitamin D: Zurück auf den Boden der Tatsachen
Wie wenigen anderen seiner Artgenossen wird Vitamin D eine Fülle von guten Eigenschaften nachgesagt: Von der Stärkung der Knochen, dem Schutz vor Krebs und Infektionen, der Senkung der Risiken durch Herzkreislauferkrankungen od...
Aktuelles
Immer auf die Ohren: Was Lärm mit uns macht
Ob wir in der Stadt oder auf dem Land leben: ständig sind wir gewollt oder ungewollt Lärm ausgesetzt, tags- und nachtsüber in der Wohnung, im Auto oder am Arbeitsplatz von Schall aus verschiedensten Quellen umgeben. Während ein...